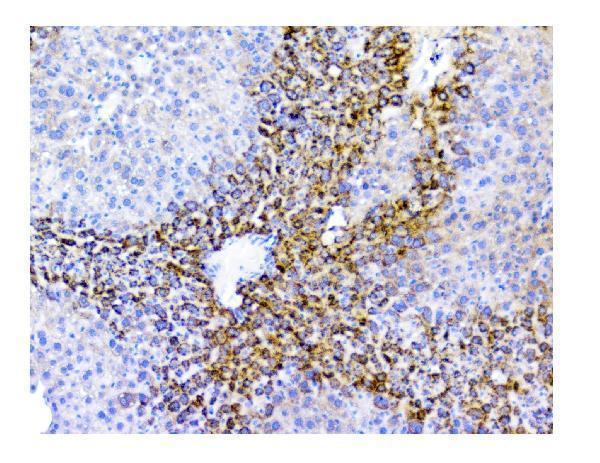
pa1955 11

Product Info Summary
| SKU: | PA1955 |
|---|---|
| Size: | 100 μg/vial |
| Reactive Species: | Human, Mouse, Rat |
| Host: | Rabbit |
| Application: | Flow Cytometry, IF, IHC, ICC, WB |
Customers Who Bought This Also Bought
Product info
Product Name
Anti-SQSTM1/p62 Antibody Picoband®
SKU/Catalog Number
PA1955
Size
100 μg/vial
Form
Lyophilized
Description
Boster Bio Anti-SQSTM1/p62 Antibody catalog # PA1955. Tested in Flow Cytometry, IF, IHC, ICC, WB applications. This antibody reacts with Human, Mouse, Rat. The brand Picoband indicates this is a premium antibody that guarantees superior quality, high affinity, and strong signals with minimal background in Western blot applications. Only our best-performing antibodies are designated as Picoband, ensuring unmatched performance.
Storage & Handling
Store at -20˚C for one year from date of receipt. After reconstitution, at 4˚C for one month. It can also be aliquotted and stored frozen at -20˚C for six months. Avoid repeated freeze-thaw cycles.
Cite This Product
Anti-SQSTM1/p62 Antibody Picoband® (Boster Biological Technology, Pleasanton CA, USA, Catalog # PA1955)
Host
Rabbit
Contents
Each vial contains antibody formulated with stabilizing components, 0.9mg NaCl, 0.2mg Na2HPO4, 0.05mg Thimerosal, 0.05mg NaN3.
*This antibody is supplied in a stabilized formulation.
Compatibility with conjugation reactions depends on the chemistry of the conjugation method used.
For conjugation methods that are not compatible with the stabilizing components present in this formulation, a carrier-free antibody format is required.
Clonality
Polyclonal
Isotype
Rabbit IgG
Immunogen
A synthetic peptide corresponding to a sequence at the N-terminus of human SQSTM1, different from the related rat and mouse sequences by one amino acid.
Cross-reactivity
No cross-reactivity with other proteins
Reactive Species
PA1955 is reactive to SQSTM1 in Human, Mouse, Rat
Observed Molecular Weight
60 kDa
Calculated molecular weight
47.7 kDa
Background of SQSTM1
SQSTM1 (Sequestosome-1), also known as Ubiquitin-Binding Protein P62 or P62, is a protein that in humans is encoded by the SQSTM1 gene. The Src homology type 2 (SH2) domain is a highly conserved motif of about 100 amino acids which mediates protein-protein interactions by binding to phosphotyrosine.p56-lck, a T-cell-specific src family tyrosine kinase with an SH2 domain, is involved in T-cell signal transduction. The International Radiation Hybrid Mapping Consortium mapped the p62 gene to chromosome 5q35. Park et al. (1995) found that the p56-lck SH2 domain binds to p62 at the ser59 of p62 only when that serine is phosphorylated. Joung et al. (1996) expressed epitope-tagged p62 in Hela cells and showed that the expressed protein bound to the lck SH2 domain and that this binding was dependent on the N-terminal 50 amino acids of p62 but not on the tyrosine residue in this region.
Antibody Validation
Boster validates all antibodies on WB, IHC, ICC, Immunofluorescence, and ELISA with known positive control and negative samples to ensure specificity and high affinity, including thorough antibody incubations.
Application & Images
Applications
PA1955 is guaranteed for Flow Cytometry, IF, IHC, ICC, WB Boster Guarantee
Recommend Dilution
| Application | Dilution | Species |
|---|---|---|
| Western blot | 0.1-0.5μg/ml | Human |
| Immunohistochemistry (Paraffin-embedded Section) | 0.5-1μg/ml | Human, Mouse, Rat |
| Immunocytochemistry/Immunofluorescence | 2μg/ml | Human |
| Flow Cytometry (Fixed) | 1-3μg/1x106 cells | Human |
Tested application
Suggested blocking solution with 5% non-fat milk or BSA; (*)Recommended protein loading: 20-40 µg per lane
Use TE buffer pH 9.0 for antigen retrieval; (*) citrate buffer pH 6.0 is an alternative.
Validation Images & Assay Conditions

Click image to see more details
Western blot analysis of SQSTM1 using anti-SQSTM1 antibody (PA1955).
Electrophoresis was performed on a 5-20% SDS-PAGE gel at 70V (Stacking gel) / 90V (Resolving gel) for 2-3 hours. The sample well of each lane was loaded with 50ug of sample under reducing conditions.
Lane 1: human Hela whole cell lysates,
Lane 2: human COLO-320 whole cell lysates,
Lane 3: human A549 whole cell lysates.
After Electrophoresis, proteins were transferred to a Nitrocellulose membrane at 150mA for 50-90 minutes. Blocked the membrane with 5% Non-fat Milk/ TBS for 1.5 hour at RT. The membrane was incubated with rabbit anti-SQSTM1 antigen affinity purified polyclonal antibody (Catalog # PA1955) at 0.5 μg/mL overnight at 4°C, then washed with TBS-0.1%Tween 3 times with 5 minutes each and probed with a goat anti-rabbit IgG-HRP secondary antibody at a dilution of 1:10000 for 1.5 hour at RT. The signal is developed using an Enhanced Chemiluminescent detection (ECL) kit (Catalog # EK1002) with Tanon 5200 system. A specific band was detected for SQSTM1 at approximately 60KD. The expected band size for SQSTM1 is at 48KD.

Click image to see more details
IHC analysis of SQSTM1 using anti-SQSTM1 antibody (PA1955).
SQSTM1 was detected in paraffin-embedded section of rat brain tissue. Heat mediated antigen retrieval was performed in EDTA buffer (pH8.0, epitope retrieval solution). The tissue section was blocked with 10% goat serum. The tissue section was then incubated with 1μg/ml rabbit anti-SQSTM1 Antibody (PA1955) overnight at 4°C. Biotinylated goat anti-rabbit IgG was used as secondary antibody and incubated for 30 minutes at 37°C. The tissue section was developed using Strepavidin-Biotin-Complex (SABC) (Catalog # SA1022) with DAB as the chromogen.

Click image to see more details
IHC analysis of SQSTM1 using anti-SQSTM1 antibody (PA1955).
SQSTM1 was detected in paraffin-embedded section of human gastric cancer tissue. Heat mediated antigen retrieval was performed in EDTA buffer (pH8.0, epitope retrieval solution). The tissue section was blocked with 10% goat serum. The tissue section was then incubated with 1μg/ml rabbit anti-SQSTM1 Antibody (PA1955) overnight at 4°C. Biotinylated goat anti-rabbit IgG was used as secondary antibody and incubated for 30 minutes at 37°C. The tissue section was developed using Strepavidin-Biotin-Complex (SABC) (Catalog # SA1022) with DAB as the chromogen.

Click image to see more details
IHC analysis of SQSTM1 using anti-SQSTM1 antibody (PA1955).
SQSTM1 was detected in paraffin-embedded section of human lung cancer tissue. Heat mediated antigen retrieval was performed in EDTA buffer (pH8.0, epitope retrieval solution). The tissue section was blocked with 10% goat serum. The tissue section was then incubated with 1μg/ml rabbit anti-SQSTM1 Antibody (PA1955) overnight at 4°C. Biotinylated goat anti-rabbit IgG was used as secondary antibody and incubated for 30 minutes at 37°C. The tissue section was developed using Strepavidin-Biotin-Complex (SABC) (Catalog # SA1022) with DAB as the chromogen.

Click image to see more details
IHC analysis of SQSTM1 using anti-SQSTM1 antibody (PA1955).
SQSTM1 was detected in paraffin-embedded section of human oesophagus squama cancer tissue. Heat mediated antigen retrieval was performed in EDTA buffer (pH8.0, epitope retrieval solution). The tissue section was blocked with 10% goat serum. The tissue section was then incubated with 1μg/ml rabbit anti-SQSTM1 Antibody (PA1955) overnight at 4°C. Biotinylated goat anti-rabbit IgG was used as secondary antibody and incubated for 30 minutes at 37°C. The tissue section was developed using Strepavidin-Biotin-Complex (SABC) (Catalog # SA1022) with DAB as the chromogen.

Click image to see more details
IHC analysis of SQSTM1 using anti-SQSTM1 antibody (PA1955).
SQSTM1 was detected in paraffin-embedded section of human rectal cancer tissue. Heat mediated antigen retrieval was performed in EDTA buffer (pH8.0, epitope retrieval solution). The tissue section was blocked with 10% goat serum. The tissue section was then incubated with 1μg/ml rabbit anti-SQSTM1 Antibody (PA1955) overnight at 4°C. Biotinylated goat anti-rabbit IgG was used as secondary antibody and incubated for 30 minutes at 37°C. The tissue section was developed using Strepavidin-Biotin-Complex (SABC) (Catalog # SA1022) with DAB as the chromogen.

Click image to see more details
IHC analysis of SQSTM1 using anti-SQSTM1 antibody (PA1955).
SQSTM1 was detected in paraffin-embedded section of human sarcoma tissue. Heat mediated antigen retrieval was performed in EDTA buffer (pH8.0, epitope retrieval solution). The tissue section was blocked with 10% goat serum. The tissue section was then incubated with 1μg/ml rabbit anti-SQSTM1 Antibody (PA1955) overnight at 4°C. Biotinylated goat anti-rabbit IgG was used as secondary antibody and incubated for 30 minutes at 37°C. The tissue section was developed using Strepavidin-Biotin-Complex (SABC) (Catalog # SA1022) with DAB as the chromogen.

Click image to see more details
IHC analysis of SQSTM1 using anti-SQSTM1 antibody (PA1955).
SQSTM1 was detected in paraffin-embedded section of human cholangiocarcinoma tissue. Heat mediated antigen retrieval was performed in EDTA buffer (pH8.0, epitope retrieval solution). The tissue section was blocked with 10% goat serum. The tissue section was then incubated with 1μg/ml rabbit anti-SQSTM1 Antibody (PA1955) overnight at 4°C. Biotinylated goat anti-rabbit IgG was used as secondary antibody and incubated for 30 minutes at 37°C. The tissue section was developed using Strepavidin-Biotin-Complex (SABC) (Catalog # SA1022) with DAB as the chromogen.

Click image to see more details
IHC analysis of SQSTM1 using anti-SQSTM1 antibody (PA1955).
SQSTM1 was detected in paraffin-embedded section of human liver cancer tissue. Heat mediated antigen retrieval was performed in EDTA buffer (pH8.0, epitope retrieval solution). The tissue section was blocked with 10% goat serum. The tissue section was then incubated with 1μg/ml rabbit anti-SQSTM1 Antibody (PA1955) overnight at 4°C. Biotinylated goat anti-rabbit IgG was used as secondary antibody and incubated for 30 minutes at 37°C. The tissue section was developed using Strepavidin-Biotin-Complex (SABC) (Catalog # SA1022) with DAB as the chromogen.

Click image to see more details
IHC analysis of SQSTM1 using anti-SQSTM1 antibody (PA1955).
SQSTM1 was detected in paraffin-embedded section of mouse brain tissue. Heat mediated antigen retrieval was performed in EDTA buffer (pH8.0, epitope retrieval solution). The tissue section was blocked with 10% goat serum. The tissue section was then incubated with 1μg/ml rabbit anti-SQSTM1 Antibody (PA1955) overnight at 4°C. Biotinylated goat anti-rabbit IgG was used as secondary antibody and incubated for 30 minutes at 37°C. The tissue section was developed using Strepavidin-Biotin-Complex (SABC) (Catalog # SA1022) with DAB as the chromogen.
Click image to see more details
IHC analysis of SQSTM1 using anti-SQSTM1 antibody (PA1955).
SQSTM1 was detected in paraffin-embedded section of rat liver tissue. Heat mediated antigen retrieval was performed in EDTA buffer (pH8.0, epitope retrieval solution). The tissue section was blocked with 10% goat serum. The tissue section was then incubated with 1μg/ml rabbit anti-SQSTM1 Antibody (PA1955) overnight at 4°C. Biotinylated goat anti-rabbit IgG was used as secondary antibody and incubated for 30 minutes at 37°C. The tissue section was developed using Strepavidin-Biotin-Complex (SABC) (Catalog # SA1022) with DAB as the chromogen.

Click image to see more details
IF analysis of SQSTM1 using anti-SQSTM1 antibody (PA1955).
SQSTM1 was detected in immunocytochemical section of A549 cells. Enzyme antigen retrieval was performed using IHC enzyme antigen retrieval reagent (AR0022) for 15 mins. The cells were blocked with 10% goat serum. And then incubated with 2μg/mL rabbit anti-SQSTM1 Antibody (PA1955) overnight at 4°C. DyLight®488 Conjugated Goat Anti-Rabbit IgG (BA1127) was used as secondary antibody at 1:100 dilution and incubated for 30 minutes at 37°C. The section was counterstained with DAPI. Visualize using a fluorescence microscope and filter sets appropriate for the label used.

Click image to see more details
Flow Cytometry analysis of A549 cells using anti-SQSTM1 antibody (PA1955).
Overlay histogram showing A549 cells stained with PA1955 (Blue line).The cells were blocked with 10% normal goat serum. And then incubated with rabbit anti-SQSTM1 Antibody (PA1955,1μg/1x106 cells) for 30 min at 20°C. DyLight®488 conjugated goat anti-rabbit IgG (BA1127, 5-10μg/1x106 cells) was used as secondary antibody for 30 minutes at 20°C. Isotype control antibody (Green line) was rabbit IgG (1μg/1x106) used under the same conditions. Unlabelled sample (Red line) was also used as a control.
Specific Publications For Anti-SQSTM1/p62 Antibody Picoband® (PA1955)
Loading publications
Recommended Resources
Here are featured tools and databases that you might find useful.
- Boster's Pathways Library
- Protein Databases
- Bioscience Research Protocol Resources
- Data Processing & Analysis Software
- Photo Editing Software
- Scientific Literature Resources
- Research Paper Management Tools
- Molecular Biology Software
- Primer Design Tools
- Bioinformatics Tools
- Phylogenetic Tree Analysis
Customer Reviews
Have you used Anti-SQSTM1/p62 Antibody Picoband®?
Share your experimental results or join a short interview to earn up to $1,000 in product credits or other rewards.
0 Reviews For Anti-SQSTM1/p62 Antibody Picoband®
Customer Q&As
Have a question?
Find answers in Q&As, reviews.
Can't find your answer?
Submit your question
16 Customer Q&As for Anti-SQSTM1/p62 Antibody Picoband®
Question
I see that the anti-SQSTM1/p62 antibody PA1955 works with ICC, what is the protocol used to produce the result images on the product page?
Verified Customer
Verified customer
Asked: 2020-04-23
Answer
You can find protocols for ICC on the "support/technical resources" section of our navigation menu. If you have any further questions, please send an email to support@bosterbio.com
Boster Scientific Support
Answered: 2020-04-23
Question
Would PA1955 anti-SQSTM1/p62 antibody work on parafin embedded sections? If so, which fixation method do you recommend we use (PFA, paraformaldehyde, other)?
P. Jones
Verified customer
Asked: 2020-04-08
Answer
As indicated on the product datasheet, PA1955 anti-SQSTM1/p62 antibody as been validated on ICC. It is best to use PFA for fixation because it has better tissue penetration ability. PFA needs to be prepared fresh before use. Long term stored PFA turns into formalin, as the PFA molecules congregate and become formalin.
Boster Scientific Support
Answered: 2020-04-08
Question
We appreciate helping with my inquiry over the phone. Here are the WB image, lot number and protocol we used for leukemic t-cell using anti-SQSTM1/p62 antibody PA1955. Let me know if you need anything else.
Verified Customer
Verified customer
Asked: 2020-03-23
Answer
Thank you for the data. You have provided everything we needed. Our lab team are working to resolve your inquiry as quickly as possible, and we appreciate your patience and understanding! Please let me know if there is anything you need in the meantime.
Boster Scientific Support
Answered: 2020-03-23
Question
Do you have a BSA free version of anti-SQSTM1/p62 antibody PA1955 available?
Verified Customer
Verified customer
Asked: 2019-12-03
Answer
I appreciate your recent telephone inquiry. I can confirm that some lots of this anti-SQSTM1/p62 antibody PA1955 are BSA free. For now, these lots are available and we can make a BSA free formula for you free of charge. It will take 3 extra days to prepare. If you require this antibody BSA free again in future, please do not hesitate to contact me and I will be pleased to check which lots we have in stock that are BSA free.
Boster Scientific Support
Answered: 2019-12-03
Question
My colleagues were content with the WB result of your anti-SQSTM1/p62 antibody. However we have observed positive staining in cervix carcinoma cytosol using this antibody. Is that expected? Could you tell me where is SQSTM1 supposed to be expressed?
Verified Customer
Verified customer
Asked: 2019-09-20
Answer
From literature, cervix carcinoma does express SQSTM1. Generally SQSTM1 expresses in cytoplasm, cytosol. Regarding which tissues have SQSTM1 expression, here are a few articles citing expression in various tissues:
B-cell, Pubmed ID: 8551575
Caudate nucleus, and Trachea, Pubmed ID: 14702039
Cervix carcinoma, Pubmed ID: 8650207, 16964243, 17081983, 18669648, 18691976, 20068231
Cervix carcinoma, and Erythroleukemia, Pubmed ID: 23186163
Leukemic T-cell, Pubmed ID: 19690332
Liver, Pubmed ID: 24275569
Pancreas, Placenta, Skin, and Uterus, Pubmed ID: 15489334
Boster Scientific Support
Answered: 2019-09-20
Question
We are currently using anti-SQSTM1/p62 antibody PA1955 for human tissue, and we are satisfied with the IHC results. The species of reactivity given in the datasheet says human, mouse, rat. Is it true that the antibody can work on pig tissues as well?
Verified Customer
Verified customer
Asked: 2019-09-04
Answer
The anti-SQSTM1/p62 antibody (PA1955) has not been validated for cross reactivity specifically with pig tissues, but there is a good chance of cross reactivity. We have an innovator award program that if you test this antibody and show it works in pig you can get your next antibody for free. Please contact me if I can help you with anything.
Boster Scientific Support
Answered: 2019-09-04
Question
Is this PA1955 anti-SQSTM1/p62 antibody reactive to the isotypes of SQSTM1?
Verified Customer
Verified customer
Asked: 2019-06-28
Answer
The immunogen of PA1955 anti-SQSTM1/p62 antibody is A synthetic peptide corresponding to a sequence at the N-terminus of human SQSTM1(91-110aa KDDIFRIYIKEKKECRRDHR), different from the related rat and mouse sequences by one amino acid. Could you tell me which isotype you are interested in so I can help see if the immunogen is part of this isotype?
Boster Scientific Support
Answered: 2019-06-28
Question
We bought anti-SQSTM1/p62 antibody for WB on leukemic t-cell in the past. I am using mouse, and I plan to use the antibody for ICC next. I would like examining leukemic t-cell as well as cervix carcinoma erythroleukemia in our next experiment. Could you please give me some suggestion on which antibody would work the best for ICC?
Verified Customer
Verified customer
Asked: 2019-06-03
Answer
I looked at the website and datasheets of our anti-SQSTM1/p62 antibody and it seems that PA1955 has been validated on mouse in both WB and ICC. Thus PA1955 should work for your application. Our Boster satisfaction guarantee will cover this product for ICC in mouse even if the specific tissue type has not been validated. We do have a comprehensive range of products for ICC detection and you can check out our website bosterbio.com to find out more information about them.
Boster Scientific Support
Answered: 2019-06-03
Question
We have been able to see staining in rat cervix carcinoma. What should we do? Is anti-SQSTM1/p62 antibody supposed to stain cervix carcinoma positively?
Verified Customer
Verified customer
Asked: 2019-04-25
Answer
According to literature cervix carcinoma does express SQSTM1. According to Uniprot.org, SQSTM1 is expressed in left adrenal gland cortex, b-cell, cervix carcinoma, caudate nucleus trachea, pancreas, placenta, skin uterus, leukemic t-cell, cervix carcinoma erythroleukemia, liver, among other tissues. Regarding which tissues have SQSTM1 expression, here are a few articles citing expression in various tissues:
B-cell, Pubmed ID: 8551575
Caudate nucleus, and Trachea, Pubmed ID: 14702039
Cervix carcinoma, Pubmed ID: 8650207, 16964243, 17081983, 18669648, 18691976, 20068231
Cervix carcinoma, and Erythroleukemia, Pubmed ID: 23186163
Leukemic T-cell, Pubmed ID: 19690332
Liver, Pubmed ID: 24275569
Pancreas, Placenta, Skin, and Uterus, Pubmed ID: 15489334
Boster Scientific Support
Answered: 2019-04-25
Question
Is a blocking peptide available for product anti-SQSTM1/p62 antibody (PA1955)?
Verified Customer
Verified customer
Asked: 2019-02-13
Answer
We do provide the blocking peptide for product anti-SQSTM1/p62 antibody (PA1955). If you would like to place an order for it please contact support@bosterbio.com and make a special request.
Boster Scientific Support
Answered: 2019-02-13
Question
I was wanting to use your anti-SQSTM1/p62 antibody for ICC for rat leukemic t-cell on frozen tissues, but I want to know if it has been tested for this particular application. Has this antibody been tested and is this antibody a good choice for rat leukemic t-cell identification?
Verified Customer
Verified customer
Asked: 2019-02-12
Answer
It shows on the product datasheet, PA1955 anti-SQSTM1/p62 antibody has been validated for IHC, ICC, WB on human, mouse, rat tissues. We have an innovator award program that if you test this antibody and show it works in rat leukemic t-cell in IHC-frozen, you can get your next antibody for free.
Boster Scientific Support
Answered: 2019-02-12
Question
My question regards using your anti-SQSTM1/p62 antibody for protein heterooligomerization studies. Has this antibody been tested with western blotting on tissue lysate? We would like to see some validation images before ordering.
Verified Customer
Verified customer
Asked: 2018-05-28
Answer
We appreciate your inquiry. This PA1955 anti-SQSTM1/p62 antibody is tested on rat intestine tissue, brain tissue, tissue lysate, hela cell lysate, u87 cell lysate, a549 cell lysate, intestinal cancer tissue. It is guaranteed to work for IHC, ICC, WB in human, mouse, rat. Our Boster guarantee will cover your intended experiment even if the sample type has not been be directly tested.
Boster Scientific Support
Answered: 2018-05-28
Question
you antibody to test anti-SQSTM1/p62 antibody PA1955 on rat leukemic t-cell for research purposes, then I may be interested in using anti-SQSTM1/p62 antibody PA1955 for diagnostic purposes as well. Is the antibody suitable for diagnostic purposes?
S. Thomas
Verified customer
Asked: 2018-03-22
Answer
The products we sell, including anti-SQSTM1/p62 antibody PA1955, are only intended for research use. They would not be suitable for use in diagnostic work. If you have the means to develop a product into diagnostic use, and are interested in collaborating with us and develop our product into an IVD product, please contact us for more discussions.
Boster Scientific Support
Answered: 2018-03-22
Question
See attached the WB image, lot number and protocol we used for leukemic t-cell using anti-SQSTM1/p62 antibody PA1955. Please let me know if you require anything else.
Verified Customer
Verified customer
Asked: 2017-08-07
Answer
Thank you very much for the data. Our lab team are working to resolve this as quickly as possible, and we appreciate your patience and understanding! You have provided everything we needed. Please let me know if there is anything you need in the meantime.
Boster Scientific Support
Answered: 2017-08-07
Question
Does anti-SQSTM1/p62 antibody PA1955 work for ICC with leukemic t-cell?
V. Wu
Verified customer
Asked: 2016-10-19
Answer
According to the expression profile of leukemic t-cell, SQSTM1 is highly expressed in leukemic t-cell. So, it is likely that anti-SQSTM1/p62 antibody PA1955 will work for ICC with leukemic t-cell.
Boster Scientific Support
Answered: 2016-10-19
Question
I have a question about product PA1955, anti-SQSTM1/p62 antibody. I was wondering if it would be possible to conjugate this antibody with biotin. I would need it to be without BSA or sodium azide. I am planning on using a buffer exchange of sodium azide with PBS only. Would there be problems for me to conjugate the antibody and store it in -20 degrees in small aliquots?
D. Rodriguez
Verified customer
Asked: 2016-05-11
Answer
We suggest not storing this antibody with PBS buffer only in -20 degrees. If you want to store it in -20 degrees it is best to add some cryoprotectant like glycerol. If you want carrier free PA1955 anti-SQSTM1/p62 antibody, we can provide it to you in a special formula with trehalose and/or glycerol. These molecules will not interfere with conjugation chemistry and provide a good level of protection for the antibody from degradation. Please be sure to specify this in your purchase order.
Boster Scientific Support
Answered: 2016-05-11





